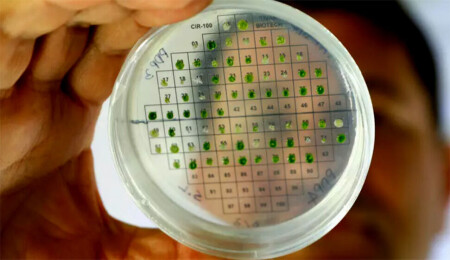

Koronavirüsün endişe yaratan Pirola varyantına dair tüm bilinenler
"Bu varyantın sivri uçlu proteininde 30'dan fazla mutasyon olması, endişelenmek için bazı nedenler sunuyor"

Pirola diye de anılan yeni Koronavirüs varyantı BA.2.86, halk sağlığı uzmanlarının endişelerini artırıyor.
ABD, Birleşik Krallık ve Çin'de Kovid-19 vakalarının yeniden artmasının ardında bu varyantın olup olmadığı tartışılıyor.
Geçen hafta ABD'de, Kovid-19 nedeniyle hastaneye kaldırılan kişi sayısında yaklaşık yüzde 19, ölümlerdeyse yüzde 18 artış yaşanmıştı.
Uzmanlar, Pirola'nın aslında Omicron suşunun yüksek oranda mutasyona uğramış bir alt varyantı olduğunu belirtiyor.
Pirola, Kovid-19 aşıların hedeflediği sivri uçlu proteindeki 35 mutasyonun sonucunda ortaya çıktı.
Virüsün yüzeyindeki sivri uçlu proteinler, patojenin insan hücrelerine girip onları enfekte etmesine olanak tanıyor. Aşılar bu nedenle söz konusu proteinleri etkisiz hale getirmeye odaklanıyor.
Varyantın bu denli çok mutasyon geçirmiş olması da pandeminin seyrini nasıl etkileyeceğine dair merak ve korku uyandırıyor.
Bulaşıcı hastalıklar uzmanı Dr. Scott Roberts, "Bu varyantın sivri uçlu proteininde 30'dan fazla mutasyon olması, endişelenmek için bazı nedenler sunuyor" dedi.
Öte yandan, Roberts, Omicron'un 2021'de ilk çıktığında da hasta sayılarında ciddi artışa neden olduğunu hatırlattı. Oysa Omicron'un hastalığın daha hafif seyretmesini sağlayarak normalleşmenin de önünü açtığı biliniyor.
Yine de uzmanlar, aşıların yeni varyant karşısında ne kadar etkili olduğunu tartışmaya devam ediyor.
Birleşik Krallık Ulusal Sağlık Ensititleri (NHS) Aşılama ve Tarama Baş Sorumlusu ve Ulusal Direktörü Steve Russell, Pirola varyatnına ilişkin yaptığı açıklamada şu ifadeleri kullandı:
Çok sayıda mutasyonun hastalığın şiddeti, aşıdan kaçma yeteneği ve bulaşıcılığı üzerindeki birleşik etkisini tahmin etmek zor. Ancak bunun Omicron'un ortaya çıkışından bu yana en endişe verici varyant olduğunda netiz.
BA.2.86 ilk olarak temmuz sonlarında Danimarka'da tespit edildi ve ağustosta ABD'de görüldü.
ABD Hastalık Kontrol Merkezleri'ne (CDC) göre Pirola varyantı İsrail, Kanada, Danimarka, Birleşik Krallık, Güney Afrika, İsveç, Norveç, İsviçre ve Tayland'da tespit edildi.
Dr. Roberts, "Diğer endişe de bu türün en az 6 ülkede tespit edilmesi ve vakaların birbiriyle alakasız olması. Bu, uluslararası toplumda tespit edemediğimiz ölçüde bulaşma olduğunu gösteriyor" diye konuştu.
Scripps Araştırma Enstitüsü müdürü Dr. Eric Topol da, Reuters'a yaptığı açıklamada varyantın hızla yayılmasının "şimdilik pek iyiye işaret olmadığını" söyledi.
Zira Dr. Topol'a göre, Pirola'nın mutasyonlarının onu daha önceki Koronavirüs varyantlarından "kökten farklı" kıldığı görüşünde.
Ancak CDC uzmanları, "Bu varyantın öncekilerle karşılaştırıldığında daha şiddetli hastalığa neden olup olmadığını bilmek için henüz çok erken" diyor.
Sağlık kurumunun varyantla ilgili açıklamasında şu ifadelere yer verildi:
BA.2.86 varyantının daha şiddetli hastalıklara neden olduğunu gösterecek olası erken sinyalleri belirlemek için hastaneye kaldırılma oranlarını yakından izliyoruz.
Öte yandan, ABD'de hastaneye kaldırılanların sayısındaki artışın muhtemelen BA.2.86'dan değil, XBB soyundan gelen virüslerden kaynaklandığı düşünülüyor.
AŞILAR GÜNCELLENİYOR
Dr. Roberts, "Asıl soru, BA.2.86'nın (vaka sayıları açısından) Omicron'la aynı üstel büyümeyi gösterip göstermeyeceği. Tamamen yok da olabilir ve bu hepimizin umduğu şey" ifadelerini kullandı.
30 Ağustos itibarıyla CDC, varyantın ABD'nin en az 4 eyaletinde insanlardan veya atık sulardan alınan örneklerde tespit edildiğini bildirmişti.
Diğer yandan Dr. Roberts'a göre iyi bir haber de var.
"İyi haber şu ki enfeksiyonlar ve aşılamalar sayesinde daha yüksek düzeyde bir sürü bağışıklığı elde ettik. Dünya 2020'de olduğu gibi şiddetli enfeksiyonlara karşı savunmasız değil" diyen bilim insanı, sözlerini şöyle sürdürdü:
SARS-CoV-2'nin orijinal versiyonundan bu yana, birçok insan enfekte oldu ve birçoğu da iyileşti. Ancak çoğumuzun son dozları olmasından bu yana bir yıl veya daha fazla zaman geçmiş olabilir. Bu nedenle herkesi eylül ortasında çıkması beklenen güncel aşıları yaptırmaya teşvik ediyorum.
Aşıların yeni varyantlara karşı güncellenme çalışmalarıysa devam ediyor.
Son olarak Avrupa Komisyonu, BionTech-Pfizer'ın Kovid-19 aşısının Omicron XBB.1 alt varyantına karşı uyarlanmış versiyonunu onaylamıştı. Bu, söz konusu aşıda üçüncü güncelleme oldu.
Bağışıklığın varyantı etkisiz hale getirme yeteneğinde yarı yarıya azalma
Biri Çin'de, diğeri İsveç'te olmak üzere iki araştırmacı grubunun bugün (4 Eylül) yayımlanan çalışmaları da Pirola endişelerine karşı yüreklere su serpen nitelikte.
Pekin Üniversitesi Biyomedikal İnovasyon Merkezi'nden araştırmacı Yunlong Cao, aşılama ve yakın zamandaki enfeksiyondan kaynaklanan bağışıklığın Pirola varyantını etkisizleştirme yeteneğinde (XBB.1.5 ailesinden gelen virüslere kıyasla) iki kat düşüş tespit edildi.
Bu ilk başta kulağa korkutucu gelse de uzmanlar çok büyük bir orana tekabül etmediğini söylüyor. Zira aşıyla oluşturulan bağışıklığın mutasyona uğramış bir grip virüsünü etkisiz hale getirmede 8 kat düşüş yaşadığı biliniyor.
Cao, CNN'e yaptığı açıklamada, "Varyantın nüfusta yavaş yavaş dolaşacağını söyleyebilirim" dedi:
Ancak ABD'de bulaşıcılık oranında baskın olan EG.5 ve FL.1.5.1 gibi varyantlara atıfta bulunarak, hızla yaygınlaşan diğer varyantlarla rekabet edemeyecek.
























Yorumlar
Dikkat!
Suç teşkil edecek, yasadışı, tehditkar, rahatsız edici, hakaret ve küfür içeren, aşağılayıcı, küçük düşürücü, kaba, müstehcen, ahlaka aykırı, kişilik haklarına zarar verici ya da benzeri niteliklerde içeriklerden doğan her türlü mali, hukuki, cezai, idari sorumluluk içeriği gönderen Üye/Üyeler’e aittir.